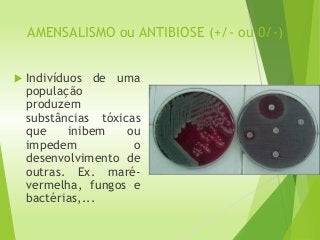
AMENSALISMO ou ANTIBIOSE (+/- ou 0/-)
 Indivíduos de uma
população
produzem
substâncias tóxicas
que inibem ou
impedem o
desenvolvimento de
outras. Ex. maré-
vermelha, fungos e
bactérias,...

Este documento descreve diferentes tipos de relações ecológicas entre organismos da mesma espécie (intra-específicas) e entre organismos de espécies diferentes (interespecíficas). As relações podem ser harmônicas, onde ambos os organismos se beneficiam, ou desarmônicas, onde pelo menos um é prejudicado. Exemplos de relações harmônicas incluem mutualismo, comensalismo e inquilinismo, enquanto competição, canibalismo e parasitismo são considerados relações desarmônicas.